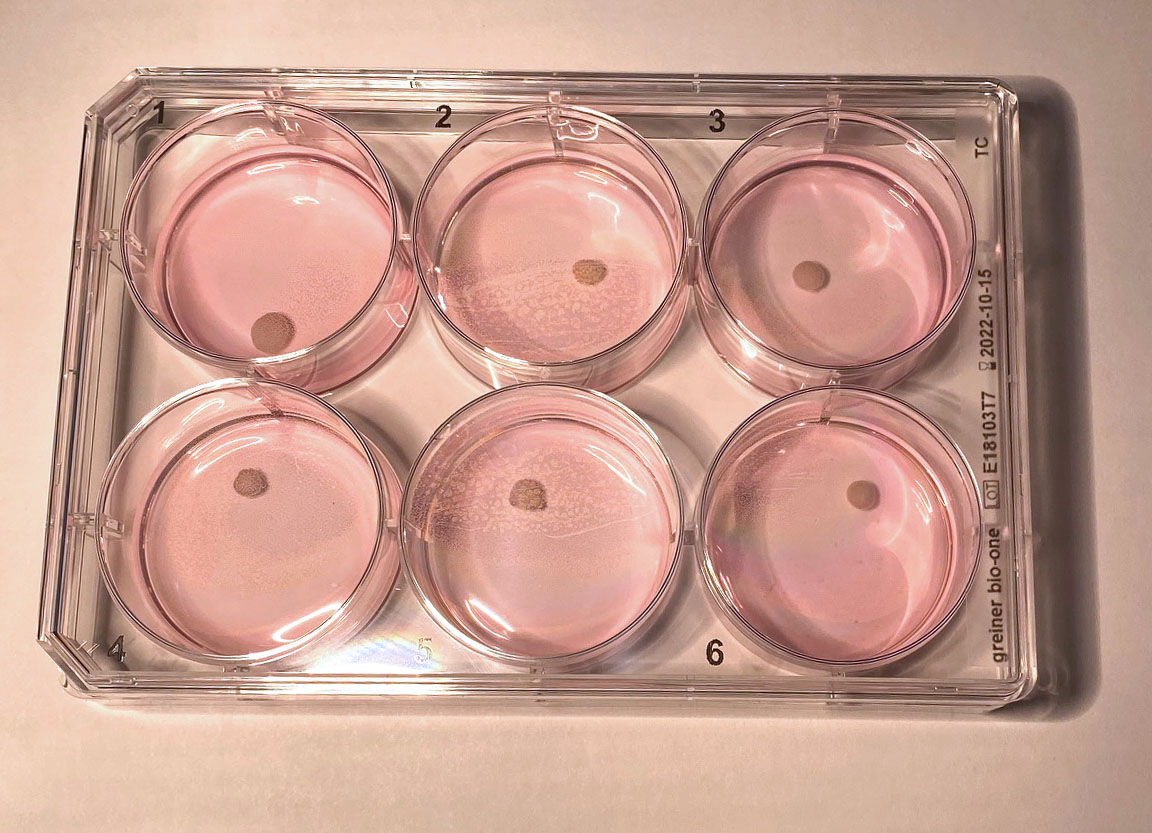
Cerebral organoid

In Vitro Genetics
We conduct unbiased, genomewide screens for quantitative trait loci (“QTL”) that modulate drug response phenotypes, combining high throughput screening methods with genetically diverse stem cells. We differentiate stem cells to therapeutically relevant cell types of interest and conduct phenotypic screens of compound action to identify genes that are causal drivers of drug response.

Leverage
Our stem cell lines constitute a permanent replicable genetic population that enables genetic screens in multiple isogenic cell types. Each new model leverages and extends the resource, enabling biological studies across panels of different cell/tissue types.
Translation
We validate the modifier genes identified in the mouse genetic screens using orthologous human iPSC derived models.
In Vitro Models
Our core resource is a collection of over 1,000 mouse ES cell lines derived from Diversity Outbred embryos. We differentiate these pluripotent stem cell lines to establish isogenic panels of lineage-restricted stem cells and terminally differentiated cell types of pharmacological interest.
We have produced 350 neural progenitor cell lines (NPCs) from the ES cell panel, and we have conducted genetic screens of 300 astrocyte lines produced from the NPCs.
eQTLs
Along with mapping QTL for functional phenotypes such as compound response, we also conduct eQTL studies using bulk and single cell transcriptomes.



Stem Cell Models
We use a proprietary panel of mouse ES and derivative lines for most genetic screens. We use human induced pluripotent stem cell lines for validation of modifier genes and mechanisms discovered in genetic screens. We also use primary cells and tissues when appropriate.
For our main genetic screening resource we produced over 1,000 ES cell lines from DO mice. The ES lines are densely genotyped and individualized genomes and transcriptomes are constructed for each cell line.
Lineage Restricted Stem Cell Banks
Pluripotent stem cell lines provide access to almost any cell type, in principle. Our cell lines are an extremely versatile, permanent and reusable resource. We are establishing lineage restricted stem cell banks by differentiation, which are themselves also permanent renewable resources for screening. These cells can be further differentiated to terminally differentiated cell types.
We have conducted genetic screens for compound/drug response genes using panels of 200-300 cell lines. These homogeneous cell models include:
- ES Cells
- Neural Progenitor Cells
- Astrocytes
- Cardiomyocytes
- Many other cell types

Organoids
Organoids are three-dimensional, self-organizing, stem-cell-derived structures that resemble their in vivo tissue counterparts. We conduct studies with organoid models because of their tissue-like organization, cell interaction, and more authentic cell types.
For analysis, we use single cell technologies such as single cell RNAseq, high content analysis imaging and FACS to manage the presence of multiple cell types within an organoid. Most of our organoid studies have been with mouse or human cerebral organoids. We have also produced intestinal, retinal and otological organoids.

Diversity Outbred Mice
Diversity Outbred (DO) mice are an outbred stock produced by many generations of random interbreeding of eight inbred founder strains. DO mice were designed for mapping complex traits and capture over 90% of the genomic variation in laboratory and wild-derived inbred mouse strains.

DO mice are available from The Jackson Laboratory (Stock # J:DO 009376).